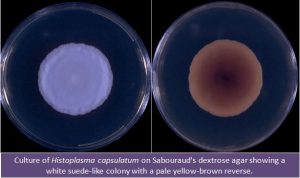
Histoplasma capsulatum culture in SDA Source:http://www.mycology.adelaide.edu.au/ - Histoplasma capsulatumculture inSDASource: http://www.mycology.adelaide.edu.au/

Histoplasma capsulatum is anintracellular, thermallydimorphicfungi (grows as a yeast in body temperature/37°C in humans, mammals, or in culture media and as mold at 25°C in environment/culture media) of medical importance that can survive within macrophages for an extended period. This fungal pathogen is associated with birds or bat droppings.
People who visit caves (researchers, spelunkers), farmers, and people who work in old buildings or any renovation project are likely to acquire this disease. Contaminated soil can be infectious for many years.
Tuberculate macroconidium (with typical thick walls and radial, finger like projections) is a diagnostic structure ofHistoplasma capsulatum.
Yeast forms of Histoplasma capsulatum are small for fungi (2 to 4 μm) and reproduce by budding (blastoconidia). The mycelia are septate and produce microconidia and macroconidia (tuberculate macroconidia).

Habitat
Histoplsama capsulatum is found throughout the world. In USA, It is endemic in Midwestern and Central USA, along the Mississippi and Ohio river valley.
Transmission and Disease
Histoplasma capsulatum causes systemic mycoses named histoplasmosis also known as darling’s disease, cave disease or spelunker’s disease. People contract this disease by the inhalation of the spore or bird or bat droppings contaminated with spores. It causes profound disease in immune-compromised (like any other fungal infection) but immune-competent people may not know that they are harboring this pathogen.
It causes systemic fungal infection (can invade other parts of the body besides lungs) which can be asymptomatic, acute, or chronic. Its acute form resembles pneumonia and chronic disease resembles tuberculosis. Immuno-compromised persons can have disseminated infections.
Note:unlike its name;Histoplasma capsulatumisnot encapsulated.The designationH.capsulatumis actually a misnomer.
Virulence factor:
- Ability to survive within the macrophage probably by modulating the pH within the phagolysome is the key virulence factor of Histoplasma capsulatum. Unlike the name suggest, this pathogen does not have capsule.
- It produces microconidia and/or small hyphal fragments of size 2-5 μm, an ideal size for alveolar deposition.
Laboratory Diagnosis

**Sample:**Bone marrow, peripheral blood, and sputum (organisms are less likely to be detected in the direct microscopic examination of respiratory tract specimens).
Methods:
- **Microscopy and Staining:**In the Wright or Giemsa stained specimens, Histoplasma capsulatum is found intracellularly within the cytoplasm of endothelial or mononuclear cells.
H capsulatum yeasts: Small round or oval cells, measuring 2-5 μm in diameter. They require differentiation from the amastigotes ofLeishmania donovaniwhich can also be found in mononuclear cells.
- Culture***:** Specimen must be cultured as soon as possible to ensure optimal recovery of H. capsulatum and other dimorphic fungi. It grows well in ordinary fungal culture media but it may be overgrown by bacteria or rapidly growing molds. It is a slow-growing mold at 25°C to 30°C and commonly requires 2-4 weeks or more for colonies to appear. The organism may, however, be recovered within 5 days or less if many yeast cells are present in the clinical specimen.
- Colony characteristics: White, fluffy mold that turns brown to buff with age. The organism may also produce wrinkle, moist, heaped, yeast-like colonies that are soft and creamy when grown at 37°C in certain media.
*****must be handled with extreme caution in aClass II Biological Safety Cabinet (BSCII).
References
- Mittal, J., Ponce, M. G., Gendlina, I., & Nosanchuk, J. D. (2019). Histoplasma Capsulatum: Mechanisms for Pathogenesis. Current topics in microbiology and immunology, 422, 157–191. https://doi.org/10.1007/82_2018_114
- Woods J. P. (2002). Histoplasma capsulatum molecular genetics, pathogenesis, and responsiveness to its environment. Fungal genetics and biology : FG & B, 35(2), 81–97. https://doi.org/10.1006/fgbi.2001.1311